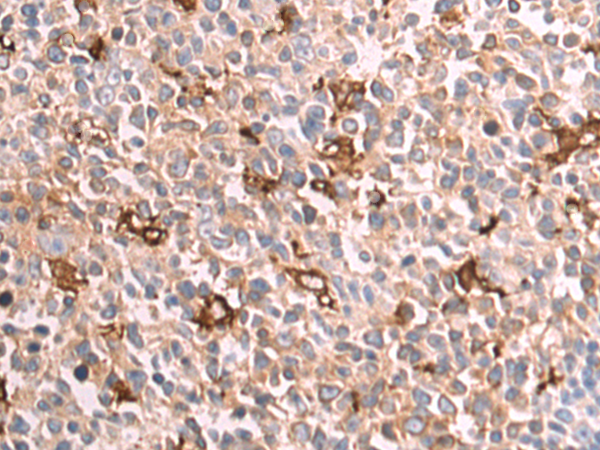

别名:LFTD; NBIA3应用:IHC
反应种属:Human
规格:50μl/100μl
| Description |
|---|
| This gene encodes the light subunit of the ferritin protein. Ferritin is the major intracellular iron storage protein in prokaryotes and eukaryotes. It is composed of 24 subunits of the heavy and light ferritin chains. Variation in ferritin subunit composition may affect the rates of iron uptake and release in different tissues. A major function of ferritin is the storage of iron in a soluble and nontoxic state. Defects in this light chain ferritin gene are associated with several neurodegenerative diseases and hyperferritinemia-cataract syndrome. This gene has multiple pseudogenes. |
| Specification | |
|---|---|
| Aliases | LFTD; NBIA3 |
| Swissprot | P02792 |
| Host/Isotype | Rabbit IgG |
| Storage | Store at 4°C short term. Aliquot and store at -20°C long term. Avoid freeze/thaw cycles. |
| Species Reactivity | Human |
| Immunogen | Fusion protein of human FTL |
| Formulation | pH7.4 PBS, 0.05% NaN3, 40% Glycerol |
| Application | |
|---|---|
| IHC | 1/50-1/200 |
| ELISA | 1/5000-1/10000 |
![]() |
The image is immunohistochemistry of paraffin-embedded Human prostate cancer tissue using P07102(FTL Antibody) at dilution 1/85. (Original magnification: ×200) |
![]() |
The image is immunohistochemistry of paraffin-embedded Human tonsil tissue using P07102(FTL Antibody) at dilution 1/85. (Original magnification: ×200) |
本公司的所有产品仅用于科学研究或者工业应用等非医疗目的,不可用于人类或动物的临床诊断或治疗,非药用,非食用。
暂无评论
本公司的所有产品仅用于科学研究或者工业应用等非医疗目的,不可用于人类或动物的临床诊断或治疗,非药用,非食用。
中文

发表回复